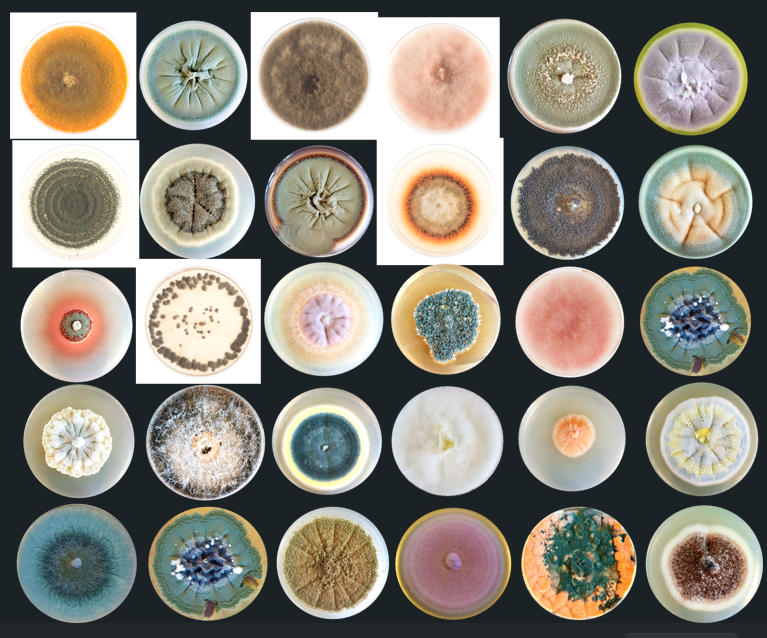

Les maladies fongiques comme le mildiou, l’oïdium et la pourriture grise affectent diverses cultures, dont la vigne. La lutte contre ces maladies est complexe, mais les recherches menées à l’Agroscope par Katia Gindro sur les champignons microscopiques permettent d’envisager de nouvelles pistes pour protéger les cultures. Exploration de l’univers des champignons microscopiques, un monde méconnu où des millions d’espèces restent à découvrir.
Une simple goutte de pluie peut contenir 10 à 15 espèces différentes de champignons. En fait, les champignons microscopiques sont présents partout. Avec d’autres micro-organismes, ils nous entourent par millions, dans l’air, dans les sols, dans l’eau douce ou l’eau de mer, dans notre corps, où ils font partie de la flore intestinale, sur les feuilles des plantes et à l’intérieur de celles-ci. On en retrouve aussi jusque dans le bois des ceps de vigne et des troncs d’arbres.
Katia Gindro, chercheuse à l’Agroscope, étudie depuis de nombreuses années cet univers encore très méconnu et souvent négligé des champignons microscopiques.
Un des buts de ses recherches est de trouver de nouveaux traitements fongicides contre les principales maladies fongiques des plantes cultivées. Certains champignons cultivables en laboratoire produisent ainsi des substances anti-fongiques, anti-bactériennes et déploient toutes sortes d’autres activités biologiques. Il s’agit aussi de mieux comprendre les maladies qui affectent nos cultures, comme la vigne, dont le mildiou, l’oïdium et la pourriture grise, qui sont toutes les trois des maladies fongiques, c’est-à-dire causées par des champignons. Au final, il s’agit de trouver de nouvelles pistes pour protéger les vignes, par exemple en identifiant des espèces capables d’occuper le terrain à la place des champignons nuisibles.

Spores de mildiou observés en fluorescence au microscope © Agroscope
De nouvelles pistes pour protéger la vigne
D’autres études menées dans les vignes ont montré qu’il y a 150 à 200 espèces de champignons à l’intérieur des ceps. L’esca, par exemple, est une maladie qui fait brusquement dépérir certains ceps. Cette maladie a longtemps été attribuée à des champignons microscopiques, capables de pénétrer dans le cep, notamment par des plaies de taille. Mais le problème est plus complexe qu’il n’y paraît : il semble résulter d’un enchaînement de troubles physiologiques chez la vigne, qui favorisent ensuite le développement de ces champignons, jusqu’à provoquer le dessèchement complet du cep.
Les champignons capables de se nourrir du bois peuvent rester des années sans causer de soucis à la vigne. Jusqu’au moment où la maladie se déclare. Le dessèchement complet du cep peut alors survenir en quelques jours, de façon aussi soudaine que spectaculaire. Le déclenchement de la maladie est assez mystérieux car les ceps qui dépérissent ont la même communauté d’espèces fongiques à l’intérieur de leur tronc que les ceps qui se portent bien.
C’est donc ailleurs qu’il faut chercher l’explication. « Ce qui déclenche l’esca est peut-être dû à un affaiblissement du cep pour cause de sécheresse ou de taille trop rude, ou encore de vignes ayant trop de vigueur. La communauté de champignons présents va alors en profiter de manière opportuniste », explique Katia Gindro, responsable du groupe mycologie de la Station fédérale de recherche Agroscope à Changins.
C’est un phénomène similaire à celui de la scepticémie chez l’être humain, une infection généralisée qui peut être mortelle. En temps normal, les staphylocoques que nous avons sur la peau ne posent pas de problème. Mais chez certaines personnes affaiblies, ces mêmes staphylocoques peuvent provoquer de graves infections.
Des millions d’espèces inconnues
Mais revenons à nos champignons. Si on connaît bien ceux visibles à l’œil nu, il reste par contre beaucoup à faire pour étudier les espèces microscopiques. Pour l’instant, 150’000 espèces sont connues et décrites, mais on estime qu’il en reste 10 millions à découvrir. L’étude de ces champignons microscopiques est encore compliquée par le fait que de nombreuses espèces sont impossibles à cultiver ou qu’il reste difficile de dissocier des communautés complexes de champignons. Autrement dit, il est parfois impossible d’isoler une espèce en particulier pour l’étudier individuellement. À commencer par certaines espèces de champignons qui font partie de notre flore intestinale. Enfin, les champignons sont très compliqués à étudier au niveau fonctionnel. « Il est souvent difficile de dire quel est leur rôle écologique précis, défense de l’hôte ou symbiose fonctionnelle. Mais de toute façon, ils sont une des composantes fondamentales de la biodiversité d’un écosystème», explique Katia Gindro.
Diverses espèces de champignons microscopiques, prélevées dans l’air ambiant puis mises en culture © Agroscope
Une biodiversité invisible
C’est pour cette raison que le projet « Life on trees », recense non seulement les mousses ou les orchidées, mais aussi les champignons que l’on trouve dans les arbres, des racines aux feuilles en passant par l’écorce. On trouve ainsi des centaines espèces différentes dans les troncs d’arbres et l’étude de deux immenses arbres, l’un au Pérou et l’autre en Colombie, ont montré qu’ils forment un écosystème en soi. Les champignons qui vivent dans le bois défendent en effet chacun leur territoire, ce qui est vrai dans n’importe quel arbre.
Chaque insecte a aussi sa communauté spécifique de myco-organismes. Il y a ainsi des champignons spécialisés qui vivent dans les insectes et d’autres qui vont les envahir et les consommer. « Quand on sauve un insecte, on sauve aussi toute une biodiversité cachée » résume Katia Gindro. Autrement dit, pour sauvegarder la biodiversité en général, il faut prendre en compte tous les organismes. Y compris ceux qui sont invisibles à l’œil nu et que l’on oublie souvent pour cette raison.
A Montricher, dans le Jura vaudois, les bois ont été mis en réserve naturelle en 2003 et les champignons microscopiques ont été inclus dans les travaux de recherche sur la biodiversité. « C’était très intéressant », relève Katia Gindro.
Hélène Koch
La Société vaudoise des Sciences Naturelles organise une fois par mois une conférence tout public sur un sujet scientifique. Voici un retour sur celle donnée par Katia Gindro, responsable du groupe mycologie de la Station fédérale de recherche Agroscope.

